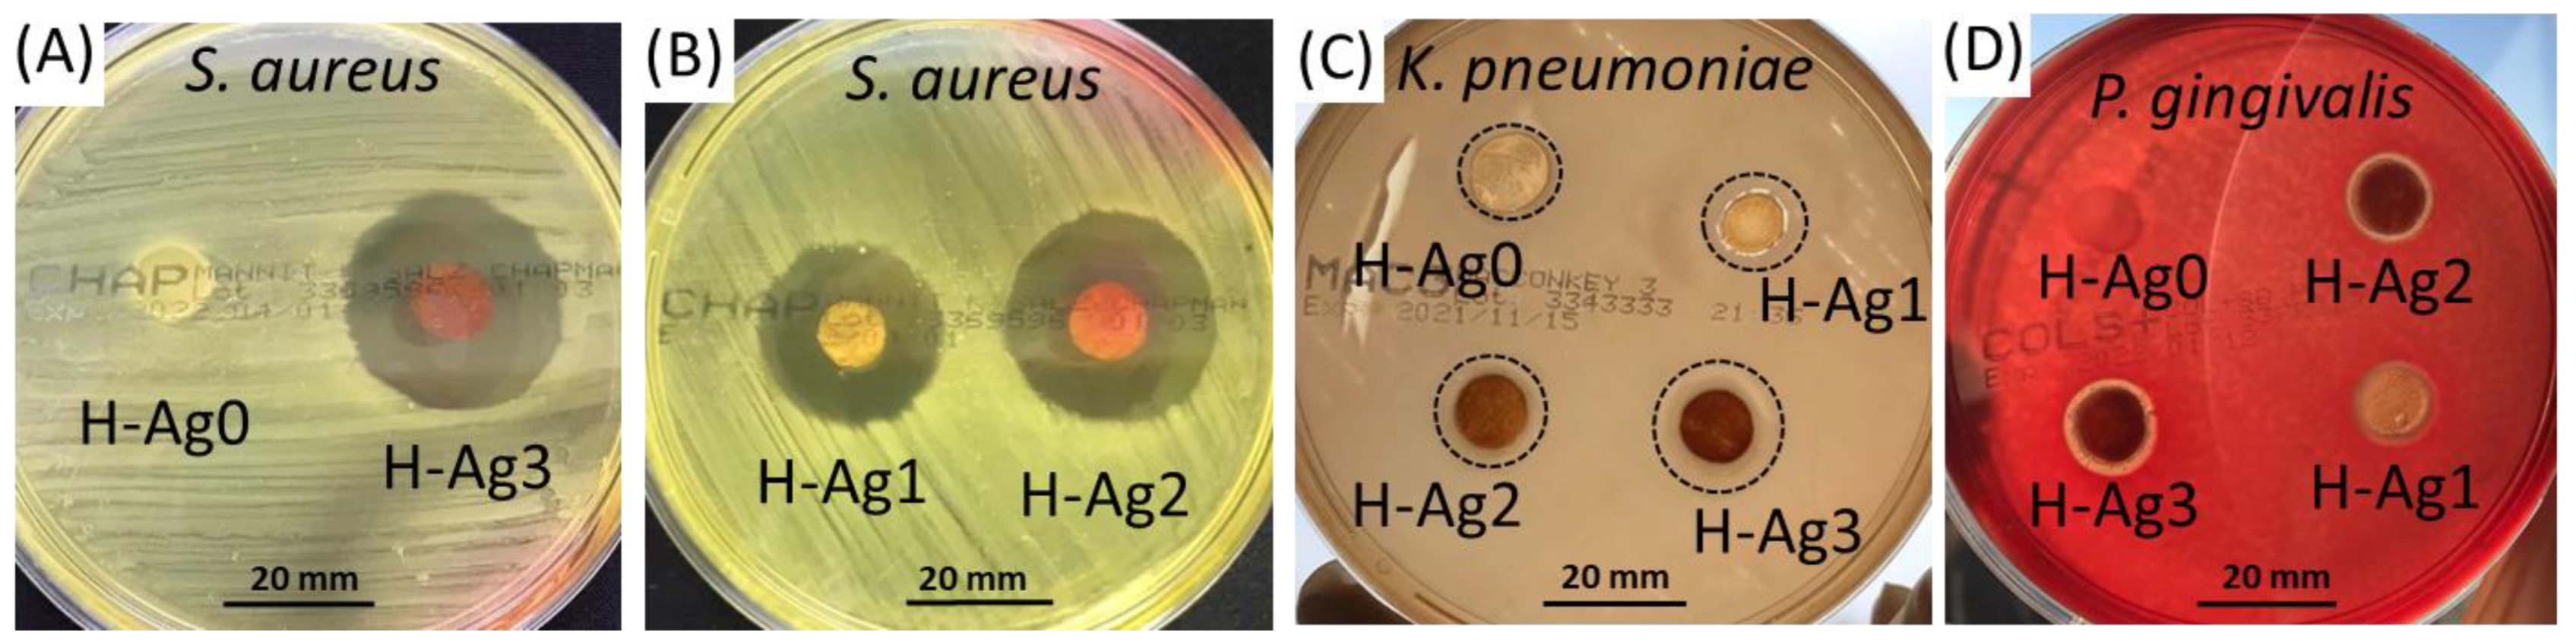

Eco-Friendly Synthesized PVA/Chitosan/Oxalic Acid Nanocomposite Hydrogels Embedding Silver Nanoparticles as Antibacterial Materials
Abstract
:1. Introduction
2. Results and Discussion
2.1. Synthesis of Chitosan-Capped Silver Nanoparticles (CS-AgNPs)
2.2. Preparation of PVA/CS/OA Hydrogels
2.3. Preparation of Composite Hydrogels Containing AgNPs
2.4. Antibacterial Studies
2.5. In Vitro Cytotoxicity Evaluation
3. Conclusions
4. Materials and Methods
4.1. Materials
4.2. Methods
4.2.1. Preparation of CS-AgNPs
4.2.2. Preparation of PVA/CS/OA Hydrogels
4.2.3. Preparation of Composite Hydrogels Containing AgNPs
4.2.4. Physicochemical Characterization
4.2.5. Antimicrobial Activity
4.2.6. Cytotoxicity Assay
4.2.7. Statistical Analysis
Author Contributions
Funding
Institutional Review Board Statement
Informed Consent Statement
Acknowledgments
Conflicts of Interest
References
- Nair, N.L.S.; Laurencin, C.T. Silver nanoparticles: Synthesis and therapeutic applications. J. Biomed. Nanotechnol. 2007, 3, 301–316. [Google Scholar] [CrossRef]
- Ahmad, S.A.; Das, S.S.; Khatoon, A.; Ansari, M.T.; Afzal, M.; Hasnain, M.S.; Nayak, A.K. Bactericidal activity of silver nanoparticles: A mechanistic review. Mater. Sci. Energy Technol. 2020, 3, 756–769. [Google Scholar] [CrossRef]
- Pangli, H.; Vatanpour, S.; Hortamani, S.; Jalili, R.; Ghahary, A. Incorporation of silver nanoparticles in hydrogel matrices for controlling wound infection. J. Burn Care Res. 2021, 42, 785–793. [Google Scholar] [CrossRef] [PubMed]
- Xie, Y.; Liao, X.; Zhang, J.; Yang, F.; Fan, Z. Novel chitosan hydrogels reinforced by silver nanoparticles with ultrahigh mechanical and high antibacterial properties for accelerating wound healing. Int. J. Biol. Macromol. 2018, 119, 402–412. [Google Scholar] [CrossRef] [PubMed]
- Martínez-Higuera, A.; Rodríguez-Beas, C.; Villalobos-Noriega, J.M.A.; Arizmendi-Grijalva, A.; Ochoa-Sánchez, C.; Larios-Rodríguez, E.; Martínez-Soto, J.M.; Rodríguez-León, E.; Ibarra-Zazueta, C.; Mora-Monroy, R.; et al. Hydrogel with silver nanoparticles synthesized by Mimosa tenuiflora for second-degree burns treatment. Sci. Rep. 2021, 11, 11312. [Google Scholar] [CrossRef]
- Rani, S.; Chandra, R.V.; Reddy, A.A.; Reddy, B.H.; Nagahajan, S.; Naveen, A. Evaluation of the antibacterial effect of silver nanoparticles on guided tissue regeneration membrane colonization—An in vitro study. J. Int. Acad. Periodontol. 2015, 17, 66–76. [Google Scholar]
- Kadam, P.; Mahale, S.; Sonar, P.; Chaudhari, D.; Shimpi, S.; Kathurwar, A. Efficacy of silver nanoparticles in chronic periodontitis patients: A clinico-microbiological study. Iberoam. J. Med. 2020, 3, 142–147. [Google Scholar] [CrossRef]
- Nešović, K.; Janković, A.; Kojić, V.; Vukašinović-Sekulić, M.; Perić-Grujić, A.; Rhee, K.Y.; Mišković-Stanković, V. Silver/poly(vinyl alcohol)/chitosan/graphene hydrogels—Synthesis, biological and physicochemical properties and silver release kinetics. Compos. Part B 2018, 154, 175–185. [Google Scholar] [CrossRef]
- Mekkawy, A.I.; El-Mokhtar, M.A.; Nafady, N.A.; Yousef, N. In vitro and in vivo evaluation of biologically synthesized silver nanoparticles for topical applications: Effect of surface coating and loading into hydrogels. Int. J. Nanomed. 2017, 12, 759–777. [Google Scholar] [CrossRef] [Green Version]
- Zakia, M.; Koo, J.M.; Kim, D.; Ji, K.; Huh, P.; Yon, J.; Yoo, S. Development of silver nanoparticle-based hydrogel composites for antimicrobial activity. Green Chem. Lett. Rev. 2020, 13, 34–40. [Google Scholar] [CrossRef] [Green Version]
- Liu, R.; Dai, L.; Si, C.; Zeng, Z. Antibacterial and hemostatic hydrogel via nanocomposite from cellulose nanofibers. Carbohydr. Polym. 2018, 195, 63–70. [Google Scholar] [CrossRef] [PubMed]
- Suflet, D.M.; Popescu, I.; Pelin, I.M.; Ichim, D.L.; Daraba, O.M.; Constantin, M.; Fundueanu, G. Dual cross-linked chitosan/PVA hydrogels containing silver nanoparticles with antimicrobial properties. Pharmaceutics 2021, 13, 146. [Google Scholar] [CrossRef] [PubMed]
- Deen, G.R.; Chua, V. Synthesis and Properties of new “stimuli” responsive nanocomposite hydrogels containing silver nanoparticles. Gels 2015, 1, 117–134. [Google Scholar] [CrossRef]
- Ganguly, S.; Das, P.; Das, T.K.; Ghosh, S.; Das, S.; Bose, M.; Mondal, M.; Das, A.K.; Das, N.C. Acoustic cavitation assisted destratified clay tactoid reinforced in situ elastomer-mimetic semi-IPN hydrogel for catalytic and bactericidal application. Ultrason. Sonochem. 2020, 60, 104797. [Google Scholar] [CrossRef] [PubMed]
- Khampieng, T.; Wongkittithavorn, S.; Chaiarwut, S.; Ekabutr, P.; Pavasant, P.; Supaphol, P. Silver nanoparticles-based hydrogel: Characterization of material parameters for pressure ulcer dressing applications. J. Drug Deliv. Sci. Technol. 2018, 44, 91–100. [Google Scholar] [CrossRef]
- Hiep, T.H.; Khon, H.C.; Niem, V.V.T.; Toi, V.V.; Quyen, T.N.; Hai, N.D.; Anh, M.N.T. Microwave-assisted synthesis of chitosan/polyvinyl alcohol silver nanoparticles gel for wound dressing applications. Int. J. Polym. Sci. 2016, 2016, 1584046. [Google Scholar] [CrossRef] [Green Version]
- Zheng, L.Y.; Zhyu, J.F. Study on antimicrobial activity of chitosan with different molecular weights. Carbohydr. Polym. 2003, 54, 527–530. [Google Scholar] [CrossRef]
- Potara, M.; Jakab, E.; Damert, A.; Popescu, O.; Canpean, V.; Astilean, S. Synergistic antibacterial activity of chitosan–silver nanocomposites on Staphylococcus aureus. Nanotechnology 2011, 22, 135101. [Google Scholar] [CrossRef]
- Wei, D.; Qian, W. Facile synthesis of Ag and Au nanoparticles utilizing chitosan as a mediator agent. Colloids Surf. B. 2008, 62, 136–142. [Google Scholar] [CrossRef]
- Biao, L.; Tan, S.; Wang, Y.; Guo, X.; Fu, Y.; Xu, F.; Zu, Y.; Liu, Z. Synthesis, characterization and antibacterial study on the chitosan-functionalized Ag nanoparticles. Mater. Sci. Eng. C 2017, 76, 73–80. [Google Scholar] [CrossRef]
- Wongpreecha, J.; Polpanich, D.; Suteewong, T.; Kaewsaneha, C.; Tangboriboonrat, P. One-pot, large-scale green synthesis of silver nanoparticles-chitosan with enhanced antibacterial activity and low cytotoxicity. Carbohydr. Polym. 2018, 199, 641–648. [Google Scholar] [CrossRef]
- Calo, E.; Khutoryanskiy, V.V. Biomedical applications of hydrogels: A review of patents and commercial products. Eur. Polym. J. 2015, 65, 252–267. [Google Scholar] [CrossRef] [Green Version]
- Das, B.; Chattopadhyay, D.; Rana, D. The gamut of perspectives, challenges and recent trends for in-situ hydrogel: A smart ophthalmic drug delivery vehicle. Biomed. Sci. 2020, 8, 4665–4691. [Google Scholar] [CrossRef] [PubMed]
- Peppas, N.A. Turbidimetric studies of aqueous poly(vinyl alcohol) solution. Die Macromol. Chem. 1975, 176, 3433–3440. [Google Scholar] [CrossRef]
- Kamoun, E.A.; Chen, X.; Eldin, M.S.M.; Kenawy, E.R.S. Crosslinked poly(vinyl alcohol) hydrogels for wound dressing applications: A review of remarkably blended polymers. Arab. J. Chem. 2015, 8, 1–14. [Google Scholar] [CrossRef] [Green Version]
- Kumar, A.; Han, S.S. PVA-based hydrogels for tissue engineering: A review. Int. J. Polym. Mater. Polym. Biomater. 2017, 66, 159–182. [Google Scholar] [CrossRef]
- Branco, A.C.; Oliveira, A.S.; Monteiro, I.; Nolasco, P.; Silva, D.C.; Figueiredo-Pina, C.G.; Colaco, R.; Serro, A.P. PVA-based hydrogels loaded with diclofenac for cartilage replacement. Gels 2022, 8, 143. [Google Scholar] [CrossRef]
- Ari, B.; Sahiner, M.; Demirci, S.; Sahiner, N. Poly(vinyl alcohol)-tannic acid cryogel matrix as antioxidant and antibacterial material. Polymers 2022, 14, 70. [Google Scholar] [CrossRef]
- Feng, P.; Luo, Y.; Ke, C.; Qiu, H.; Wang, W.; Zhu, Y.; Hou, R.; Xu, L.; Wu, S. Chitosan-based functional materials for skin wound repair: Mechanisms and applications. Front. Bioeng. Biotechnol. 2021, 9, 650598. [Google Scholar] [CrossRef]
- Sahiner, N.; Sagbas, S.; SAhiner, M.; Silan, C.; Aktas, N.; Turk, M. Agar/chitosan IPN thin hydrogel films with antimicrobial and antioxidant properties for potential dressing applications. Curr. Appl. Polym. Sci. 2017, 1, 52–62. [Google Scholar] [CrossRef]
- Sung, J.H.; Hwang, M.R.; Kim, J.O.; Lee, J.H.; Kim, Y.I.; Kim, J.H.; Chang, S.W.; Jin, S.G.; Kim, J.A.; Lyoo, W.S.; et al. Gel characterisation and in vivo evaluation of minocycline-loaded wound dressing with enhanced wound healing using polyvinyl alcohol and chitosan. Int. J. Pharm. 2010, 392, 232–240. [Google Scholar] [CrossRef] [PubMed]
- Cascone, M.G.; Maltinti, S.; Barbani, N.; Laus, M. Effect of chitosan and dextran on the properties of poly(vinyl alcohol) hydrogels. J. Mater. Sci. Mater. Med. 1999, 10, 431–435. [Google Scholar] [CrossRef] [PubMed]
- Abdel-Mohsen, A.M.; Aly, A.S.; Hrdina, R.; Montaser, A.S.; Hebeish, A. Eco-synthesis of PVA/chitosan hydrogels for biomedical application. J. Polym. Environ. 2011, 19, 1005–1012. [Google Scholar] [CrossRef]
- Figueroa-Pizano, M.D.; Vélaz, I.; Peñas, F.J.; Zavala-Rivera, P.; Rosas-Durazo, A.J.; Maldonado-Arce, A.D.; Martínez-Barbosa, M.E. Effect of freeze-thawing conditions for preparation of chitosan-poly (vinyl alcohol) hydrogels and drug release studies. Carbohydr. Polym. 2018, 195, 476–485. [Google Scholar] [CrossRef] [PubMed]
- Yang, X.; Liu, Q.; Chen, X.; Yu, F.; Zhu, Z. Investigation of PVA/ws-chitosan hydrogels prepared by combined c-irradiation and freeze-thawing. Carbohydr. Polym. 2008, 73, 401–408. [Google Scholar] [CrossRef]
- Vrana, N.E.; Liu, Y.; McGuiness, G.B.; Cahill, P.A. Characterization of poly(vinyl alcohol)/chitosan hydrogels as vascular tissue engineering scaffolds. Macromol. Symp. 2008, 269, 106–110. [Google Scholar] [CrossRef]
- Mathews, D.T.; Birney, Y.A.; Cahill, P.A.; McGuinness, G.B. Mechanical and morphological characteristics of poly(vinyl alcohol)/chitosan hydrogels. J. Appl. Polym. Sci. 2008, 109, 1129–1137. [Google Scholar] [CrossRef]
- Chen, P.H.; Kuo, T.Y.; Liu, F.H.; Hwang, Y.H.; Ho, M.H.; Wang, D.M.; Lai, J.Y.; Hsieh, H.J. Use of dicarboxylic acids to improve and diversify the material properties of porous chitosan membranes. J. Agric. Food Chem. 2008, 56, 9015–9021. [Google Scholar] [CrossRef]
- Sailakshmi, G.; Mitra, T.; Chatterjee, S.; Gnanamani, A. Engineering chitosan using α,ω-dicarboxylic acids—An approach to improve the mechanical strength and thermal stability. J. Biomater. Nanobiotechnol. 2013, 4, 151–164. [Google Scholar] [CrossRef] [Green Version]
- Fadzallah, I.A.; Majid, S.R.; Careem, M.A.; Arof, A.K. A study on ionic interactions in chitosan–oxalic acid polymer electrolyte membranes. J. Membr. Sci. 2014, 463, 65–72. [Google Scholar] [CrossRef]
- Nguyen, T.D.; Nguyen, T.T.; Ly, K.L.; Tran, A.H.; Nguyen, T.T.N.; Vo, M.T.; Ho, H.M.; Dang, N.T.N.; Vo, V.T.; Nguyen, D.H.; et al. In vivo study of the antibacterial chitosan/polyvinyl alcohol loaded with silver nanoparticle hydrogel for wound healing applications. Int. J. Polym. Sci. 2019, 2019, 7382717. [Google Scholar] [CrossRef]
- Khorasani, M.T.; Joorabloo, A.; Moghaddam, A.; Shamsi, H.; Moghadam, Z.M. Incorporation of ZnO nanoparticles into heparinised polyvinyl alcohol/chitosan hydrogels for wound dressing application. Int. J. Biol. Macromol. 2018, 114, 1203–1215. [Google Scholar] [CrossRef]
- Nguyen, N.-T.; Liu, J.-H. A green method for in situ synthesis of poly(vinyl alcohol)/chitosan hydrogel thin films with entrapped silver nanoparticles. J. Taiwan Inst. Chem. Eng. 2014, 45, 2827–2833. [Google Scholar] [CrossRef]
- Agnihotri, S.; Mukherji, S.; Mukherji, S. Antimicrobial chitosan-PVA hydrogel as nanoreactor and immobilizing matrix for silver nanoparticles. Appl. Nanosci. 2012, 2, 179–188. [Google Scholar] [CrossRef] [Green Version]
- Nasef, S.M.; Khozemy, E.E.; Kamoun, E.A.; El-Gendi, H. Gamma radiation-induced crosslinked composite membranes based on polyvinyl alcohol/chitosan/AgNO3/vitamin E for biomedical applications. Int. J. Biol. Macromol. 2019, 137, 878–885. [Google Scholar] [CrossRef]
- Rinehart, S.J.; Campbell, T.D.; Burke, K.J.; Garcia, B.; Mlynarski, A.; Brain, S.J.; Truffa, J.M.; Rago, J.; Chura, W.E.; Keleher, J.J. Synthesis and characterization of a chitosan/PVA antimicrobial hydrogel nanocomposite for responsive wound management materials. J. Microb. Biochem. Technol. 2016, 8, 065–070. [Google Scholar] [CrossRef]
- Nguyen, X.T.; Van Toi, V.; Nguyen, T.H. Development of a new injectable PVA–Ag Nps/ chitosan hydrogel for wound dressing application. In Proceedings of the 5th International Conference on Biomedical Engineering in Vietnam, Proceedings of the IFMBE Proceedings, Ho Chi Minh City, Vietnam, 16–18 June 2014; Toi, V., Lien Phuong, T., Eds.; Springer: Cham, Switzerland, 2015. [Google Scholar] [CrossRef]
- Murugadoss, A.; Chattopadhyay, A. A ‘green’ chitosan–silver nanoparticle composite as a heterogeneous as well as micro-heterogeneous catalyst. Nanotechnology 2007, 19, 015603. [Google Scholar] [CrossRef]
- Xie, J.; Lee, J.Y.; Wang, D.I.C.; Ting, Y.P. Silver nanoplates: From biological to biomimetic synthesis. ACS Nano 2007, 1, 429–439. [Google Scholar] [CrossRef]
- Paramelle, D.; Sadovoy, A.; Gorelik, S.; Free, P.; Hobley, J.; Fernig, D.G. A rapid method to estimate the concentration of citrate capped silver nanoparticles from UV-visible light spectra. Analyst 2014, 139, 4855. [Google Scholar] [CrossRef]
- Kumar-Krishnan, S.; Prokhorov, E.; Hernández-Iturriaga, M.; Mota-Morales, J.D.; Vázquez-Lepe, M.; Kovalenko, Y.; Sanchez, I.C.; Luna-Bárcenas, G. Chitosan/silver nanocomposites: Synergistic antibacterial action of silver nanoparticles and silver ions. Eur. Polym. J. 2015, 67, 242–251. [Google Scholar] [CrossRef]
- Agnihotri, S.; Mukherji, S.; Mukherji, S. Size-controlled silver nanoparticles synthesized over the range 5–100 nm using the same protocol and their antibacterial efficacy. RSC Adv. 2014, 4, 3974–3983. [Google Scholar] [CrossRef] [Green Version]
- Li, J.; Zhuang, S. Antibacterial activity of chitosan and its derivatives and their interaction mechanism with bacteria: Current state and perspectives. Eur. Polym. J. 2020, 138, 109984. [Google Scholar] [CrossRef]
- Holloway, J.L.; Lowman, A.M.; Palmese, G.R. The role of crystallization and phase separation in the formation of physically cross-linked PVA hydrogels. Soft Matter 2013, 9, 826–833. [Google Scholar] [CrossRef]
- Ghosh, A.; Ali, M.A. Studies on physicochemical characteristics of chitosan derivatives with dicarboxylic acids. J. Mater. Sci. 2012, 47, 1196–1204. [Google Scholar] [CrossRef]
- Hamdine, M.; Heuzey, M.C.; Bégin, A. Effect of organic and inorganic acids on concentrated chitosan solutions and gels. Int. J. Biol. Macromol. 2005, 37, 134–142. [Google Scholar] [CrossRef]
- Hamdine, M.; Heuzey, M.C.; Bégin, A. Viscoelastic properties of phosphoric and oxalic acid-based chitosan hydrogels. Rheol. Acta 2006, 45, 659–675. [Google Scholar] [CrossRef]
- Wu, M.; Chen, X.; Xu, J.; Zhang, H. Freeze-thaw and solvent-exchange strategy to generate physically cross-linked organogels and hydrogels of curdlan with tunable mechanical properties. Carbohydr. Polym. 2022, 287, 119003. [Google Scholar] [CrossRef]
- Butylina, S.; Geng, S.; Oksman, K. Properties of as-prepared and freeze-dried hydrogels made from poly(vinyl alcohol) and cellulose nanocrystals using freeze-thaw technique. Eur. Polym. J. 2016, 81, 386–396. [Google Scholar] [CrossRef]
- Tang, Y.F.; Du, Y.M.; Hu, X.W.; Shi, X.W.; Kennedy, J.F. Rheological characterisation of a novel thermosensitive chitosan/poly(vinyl alcohol) blend hydrogel. Carbohydr. Polym. 2007, 67, 491–499. [Google Scholar] [CrossRef]
- Cataliotti, R.S.; Aliotta, F.; Ponterio, R. Silver nanoparticles behave as hydrophobic solutes towards the liquid water structure in the interaction shell. A Raman study in the O–H stretching region. Phys. Chem. Chem. Phys. 2009, 11, 11258–11263. [Google Scholar] [CrossRef]
- Aziz, S.B.; Abdulwahid, R.T.; Rasheed, M.A.; Abdullah, O.G.; Ahmed, H.M. Polymer blending as a novel approach for tuning the SPR peaks of silver nanoparticles. Polymers 2017, 9, 486. [Google Scholar] [CrossRef] [PubMed]
- Kumar, H.M.P.N.; Prabhakar, M.N.; Venkata, P.C.; Rao, K.M.; Reddy, T.V.A.K.; Rao, K.C.; Subha, M.C.S. Compatibility studies of chitosan/PVA blend in 2% aqueous acetic acidsolution at 30 °C. Carbohydr. Polym. 2010, 82, 251–255. [Google Scholar] [CrossRef]
- Bahador, A.; Pourakbari, B.; Bolhari, B.; Hashemi, F.B. In vitro evaluation of the antimicrobial activity of nanosilver-mineral trioxide aggregate against frequent anaerobic oral pathogens by a membrane-enclosed immersion test. Biomed. J. 2015, 38, 77–83. [Google Scholar] [CrossRef]
- Halkai, K.R.; Mudda, J.A.; Shivanna, V.; Rathod, V.; Halkai, R.S. Evaluation of antibacterial efficacy of biosynthesized silver nanoparticles derived from fungi against endo-perio pathogens Porphyromonas gingivalis, Bacillus pumilus, and Enterococcus faecalis. J. Conserv. Dent. 2017, 20, 398–404. [Google Scholar] [CrossRef] [PubMed]
- Beer, C.; Foldbjerg, R.; Hayashi, Y.; Sutherland, D.S.; Autrup, H. Toxicity of silver nanoparticles—Nanoparticle or silver ion? Toxicol. Lett. 2012, 208, 286–292. [Google Scholar] [CrossRef] [PubMed]
- Gamzazade, A.I.; Slimak, V.M.; Skljar, A.M.; Stykova, E.V.; Pavlova, S.S.A.; Rogozin, S.V. Investigation of the hydrodynamic properties of chitosan solutions. Acta Polym. 1985, 36, 420–424. [Google Scholar] [CrossRef]
- Leane, M.M.; Nankervis, R.; Smith, A.; Illum, L. Use of ninhydrin assay to measure the release of chitosan from oral solid dosage forms. Int. J. Pharm. 2004, 271, 241–249. [Google Scholar] [CrossRef]
- Prochazkova, S.; Vårum, K.M.; Østgaard, K. Quantitative determination of chitosans by ninhydrin. Carbohydr. Polym. 1999, 38, 115–122. [Google Scholar] [CrossRef]
- Popescu, I.; Pelin, I.M.; Ailiesei, G.L.; Ichim, D.L.; Suflet, D.M. Amphiphilic polysaccharide based on curdlan: Synthesis and behaviour in aqueous solution. Carbohydr. Polym. 2019, 224, 115157. [Google Scholar] [CrossRef]
- Hudzicki, J. Kirby-Bauer Disk Diffusion Susceptibility Test Protocol; American Society for Microbiology: Washington, DC, USA, 8 December 2009; Available online: https://asm.org/getattachment/2594ce26-bd44-47f6-8287-0657aa9185ad/Kirby-Bauer-Disk-Diffusion-Susceptibility-Test-Protocol-pdf.pdf (accessed on 17 November 2021).

| Preparation | Compression after F-T Cycles | Gel Fraction (%) | |||
|---|---|---|---|---|---|
| PVA:CS (wt:wt) | OA:CS (wt:wt) | Number of F-T Cycles | E (kPa) | Ultimate Compressive Strength (kPa) | |
| 50:50 | 0.75:1 | 3 | 5.0 (±0.4) | 2.7 (±0.1) | 31.8 (±1.2) |
| 4 | 8.3 (±0.15) | 5.0 (±0.3 | 39.6 (±2.1) | ||
| 5 | 10.1 (±0.2) | 7.3 (±0.1) | 48.9 (±0.8) | ||
| 6 | 10.5 (±0.1) | 8.1 (±0.2) | 52.6 (±0.8) | ||
| 7 | 11.0 (±0.5) | 10.9 (±0.6) | 56.0 (±0.7) | ||
| 50:50 | 0:1 * | 7 | 3.5 (±0.6) | 9.4 (±0.4) | 39.9 (±1.9) |
| 0.5:1 | 4.5 (±0.9) | 5.6 (±0.6) | 49.3 (±1.6) | ||
| 0.6:1 | 8.1 (±0.7) | 6.8 (±0.3) | 53.1 (±0.7) | ||
| 0.75:1 | 11.0 (±0.5) | 10.9 (±0.9) | 57.3 (±1.2) | ||
| 1:1 | 11.6 (±0.9) | 11.8 (±1.1) | 56.0 (±0.7) | ||
| 1.25:1 | 10.2 (±2.2) | 7.8 (±0.8) | 55.2 (±0.9) | ||
| 100:0 | 1:1 | 7 | 10.6 (±0.4) | - | 89 (±0.8) |
| 75:25 | 7.8 (±0.4) | 25.7 (±1.1) | 66.2 (±1.6) | ||
| 50:50 | 11.6 (±0.9) | 11.8 (±1.1) | 56.0 (±0.7) | ||
| 25:75 | 16.3 (±0.6) | 9.8 (±0.5) | 52.1 (±1.2) | ||
| 1:100 | 5.4 (±1.0) | 1.2 (±0.1) | 49.2 (±2.2) | ||
| PVA:CS:OA (wt:wt:wt) | CS Content, wt% | |
|---|---|---|
| Theoretical | Ninhydrin Assay | |
| 75:25:25 | 20 | 21.3 (±0.7) |
| 50:50:50 | 33.3 | 46.9 (±1.8) |
| 25:75:75 | 42.8 | 67.7 (±2.1) |
| 0:100:100 | 50 | 73.1 (±0.2) |
| Sample | PVA:CS: CS-AgNPs:OA (wt:wt:wt:wt) | Ag Content (wt %) | Compression after F-T Cycles | Gel Fraction (%) | Swelling Ratio (g/g) | |||
|---|---|---|---|---|---|---|---|---|
| Theoretical | from AAS | E (kPa) | Ultimate Compressive Stress (kPa) | PB, pH = 7.4 | PB, pH = 5.4 | |||
| H-Ag0 | 50:50:0:50 | 0 | - | 11.6 (±0.9) | 11.8 (±1.1) | 56.0 (±0.7) | 18.0 (±0.5) | 22.3 (±1.1) |
| H-Ag1 | 50:48.6:1.7:50 | 0.2 | 0.33 | 11.8 (±0.2 | 11.8 (±0.8) | 56.8 (±0.8) | 18.6 (±0.5) | 22.2 (±1.0) |
| H-Ag2 | 50:47.3:3.3:50 | 0.4 | 0.76 | 11.3 (±0.8) | 12.6 (±0.7) | 55.5 (±1.1) | 18.8 (±0.6) | 22.9 (±1.2) |
| H-Ag3 | 50:44.5:6.7:50 | 0.8 | 1.4 | 11.6 (±0.4) | 13.6 (±0.6) | 56.9 (±0.9) | 16.5 (±0.5) | 22.6 (±0.9) |
| H-Ag4 | 50:39.1:13.3:50 | 1.6 | 2.8 | 10.6 (±0.5) | 15.3 (±0.5) | 54.8 (±0.7) | 15.5 (±0.3) | 21.9 (±1.3) |
| H-Ag5 | 50:28.1:26.7:50 | 3.1 | 4.4 | 8.4 (±0.5) | 11.5 (±0.2) | 47.3 (±1.6) | 15.0 (±1.0) | 21.6 (±0.9) |
| H-Ag6 | 50:9:50:50 | 8.3 | n.d. | 6.8 (±0.2) | 9.6 (±0.9) | 44.7 (±1.3) | 14.9 (±0.9) | 19.6 (±0.8) |
| Diameter of the Inhibition Zone (mm) | ||||
|---|---|---|---|---|
| Hydrogel | H-Ag0 | H-Ag1 | H-Ag2 | H-Ag3 |
| Organism | ||||
| Staphylococcus aureus | 10 | 22 | 26 | 26 |
| Klebsiella pneumoniae | 13 | 14 | 15 | 17.5 |
| Porphyromonas gingivalis | - | 11.5 | 12 | 13 |
Publisher’s Note: MDPI stays neutral with regard to jurisdictional claims in published maps and institutional affiliations. |
© 2022 by the authors. Licensee MDPI, Basel, Switzerland. This article is an open access article distributed under the terms and conditions of the Creative Commons Attribution (CC BY) license (https://creativecommons.org/licenses/by/4.0/).
Share and Cite
Popescu, I.; Constantin, M.; Pelin, I.M.; Suflet, D.M.; Ichim, D.L.; Daraba, O.M.; Fundueanu, G. Eco-Friendly Synthesized PVA/Chitosan/Oxalic Acid Nanocomposite Hydrogels Embedding Silver Nanoparticles as Antibacterial Materials. Gels 2022, 8, 268. https://doi.org/10.3390/gels8050268
Popescu I, Constantin M, Pelin IM, Suflet DM, Ichim DL, Daraba OM, Fundueanu G. Eco-Friendly Synthesized PVA/Chitosan/Oxalic Acid Nanocomposite Hydrogels Embedding Silver Nanoparticles as Antibacterial Materials. Gels. 2022; 8(5):268. https://doi.org/10.3390/gels8050268
Chicago/Turabian StylePopescu, Irina, Marieta Constantin, Irina M. Pelin, Dana M. Suflet, Daniela L. Ichim, Oana M. Daraba, and Gheorghe Fundueanu. 2022. "Eco-Friendly Synthesized PVA/Chitosan/Oxalic Acid Nanocomposite Hydrogels Embedding Silver Nanoparticles as Antibacterial Materials" Gels 8, no. 5: 268. https://doi.org/10.3390/gels8050268
APA StylePopescu, I., Constantin, M., Pelin, I. M., Suflet, D. M., Ichim, D. L., Daraba, O. M., & Fundueanu, G. (2022). Eco-Friendly Synthesized PVA/Chitosan/Oxalic Acid Nanocomposite Hydrogels Embedding Silver Nanoparticles as Antibacterial Materials. Gels, 8(5), 268. https://doi.org/10.3390/gels8050268

